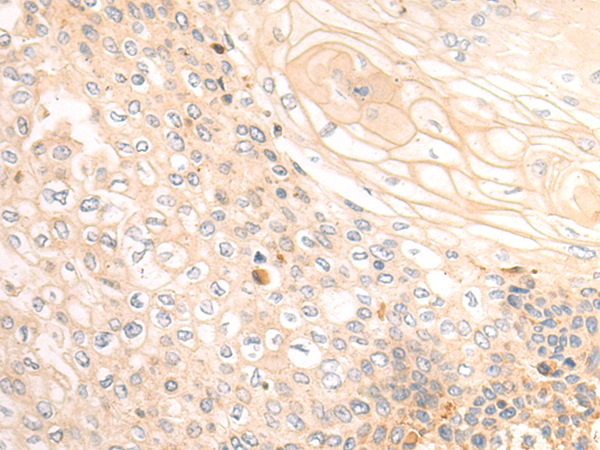
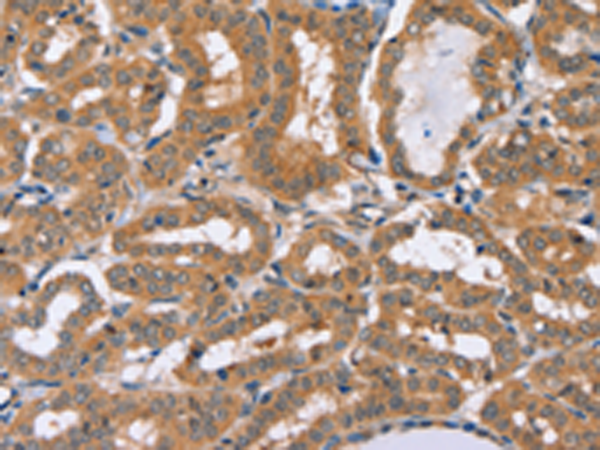
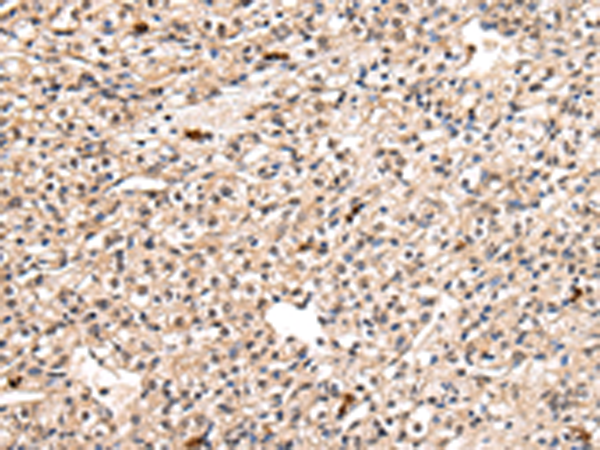

-
分类: 科研抗体货号: P08642别名: MAPE; OIP4; CT130; OIP-4应用: IHC反应种属: Human
-
分类: 科研抗体货号: P08621别名: RD; LN1; PAHX; LNAP1; PHYH1应用: WB,IHC反应种属: Human, Mouse
-
分类: 科研抗体货号: P08605别名: PDGRL; PRLTS应用: WB,IHC反应种属: Human, Mouse, Rat
-
分类: 科研抗体货号: P08640别名: PDH; PDP; PDPC; PPM2A; PPM2C应用: WB,IHC反应种属: Human, Mouse, Rat
-
分类: 科研抗体货号: P08620别名: PHLPP1应用: IHC反应种属: Human, Mouse, Rat
-
分类: 科研抗体货号: P08604别名: IEGF; SCDGFB; MSTP036; SCDGF-B应用: IHC反应种属: Human, Mouse, Rat
-
分类: 科研抗体货号: P08639别名: CYPL1; hCyPX; PPIase; CGI-124应用: WB,IHC反应种属: Human, Mouse
-
分类: 科研抗体货号: P08619别名:应用: IHC反应种属: Human, Mouse
-
分类: 科研抗体货号: P08631别名: PLZF; ZNF145应用: WB反应种属: Human
-
分类: 科研抗体货号: P08638别名: CYP; SRCyp; SCAF10; CARS-Cyp应用: IHC反应种属: Human, Mouse, Rat

鄂公网安备42018502007531号
鄂公网安备42018502007531号

